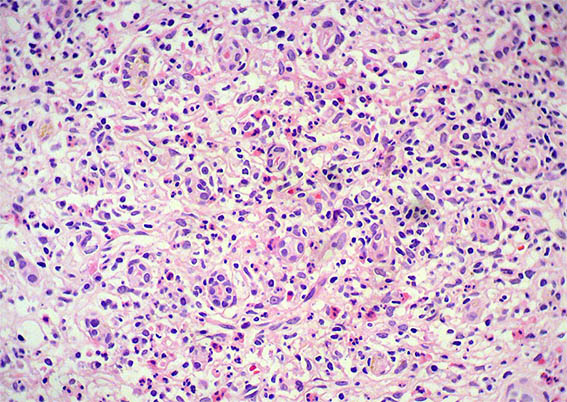
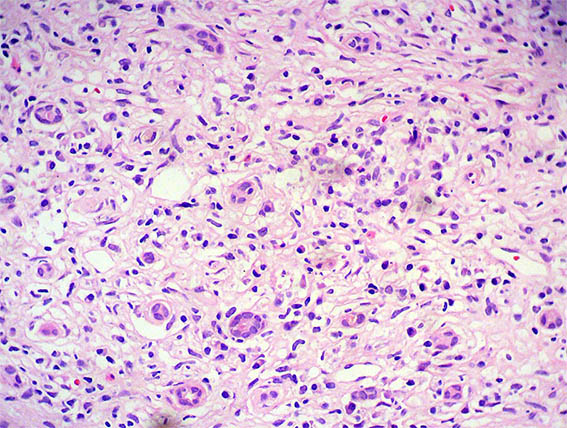

|
|
CASO
185 (julio de 2021)
Datos clínicos:
El paciente es un hombre de 38 años, presenta síntomas constitucionales de 6 meses de evolución, pérdida de peso, aproximadamente 10 kg, fiebre intermitente de predominio nocturno y elevación progresiva de creatinina sérica, con una elevación reciente abrupta hasta 8 mg/dL, requiriendo diálisis.
Estudios de autoinmunidad negativos, excepto por leve disminución del C3: 84 mg/dL (90-180), C3: 20,2 (12-40), con ANAs y anti-DNA negativos. Bioquímica hepática normal. Estudios para virus negativos. PTH: 110 pg/mL, perfil de SAF: negativo. Electroforesis sin pico monoclonal. LDH: normal; velocidad de sedimentación globular (VSG): 120 mm/h. Por ecografía: riñones aumentados de tamaño, con mala diferenciación corticomedular. Proteinuria: 700 mg/24h, en el sedimento 3 eritrocitos/CGA, leucocitos: 6/CGA. Se documentan adenomegalias inguinales, periaórticas y retroperitoneales.
Se hace biopsia renal. Observe las imágenes.

Figura 1. H&E, X100. Note el prominente compromiso tubulointersticial.

Figura 2. H&E, X200.
Figura 3.
H&E, X400. Infiltrado intersticial de linfocitos, neutrófilos, eosinófilos y células plasmáticas.

Figura 4. H&E, X400.
Figura 5. H&E, X400.

Figura 6. PAS, X100. Notoria fibrosis y atrofia tubular.

Figura 7. Plata-metenamina, X100.

Figura 8. Plata-metenamina, X400. Glomérulos con características normales.

Figura 9. Inmunohistoquímica para IgG, X200. Abundantes células plasmática positivas para IgG, muchas de ellas IgG4: ver las imágenes 11 y 12.

Figura 10. Inmunohistoquímica para IgG, X400.

Figura 11. Inmunohistoquímica para IgG4, X200.

Figura 12. Inmunohistoquímica para IgG4, X400.
Inmunofluorescencia directa para IgA, IgG, IgM, C3, C1q, kappa y lambda: Negativas en glomérulos, basales tubulares e intersticio.
¿Cuál es su diagnóstico?
Ver
diagnóstico y discusión
[Arriba]
|
|